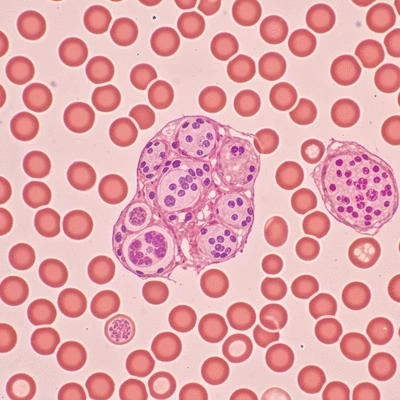
Microscopic view of blood cells showing both healthy and abnormal leukemia cells, clean image, no text, no words, no typography

Types of Leukemia and Differences
Knowledge is a powerful tool. In the world of healthcare, especially when it comes to complex illnesses like leukemia, understanding your condition can drastically change the course of your treatment and overall experience. As you prepare to delve into the nuances of leukemia, consider how awareness can empower you and provide a clearer path forward.
What You Will Learn
- Leukemia is categorized into two main types: acute and chronic, each with distinct characteristics and treatment approaches.
- Recognizing the unique symptoms of different leukemia types is crucial for timely diagnosis and intervention.
- Understanding diagnostic procedures, such as blood tests and bone marrow biopsies, can help ease anxiety about the diagnosis process.
- Knowledge about clinical trials can provide access to innovative treatments and contribute to leukemia research.
- Engaging with support organizations can enhance your journey by providing education, resources, and a community of shared experiences.
Understanding Leukemia: Acute vs. Chronic & Diagnostic Pathways
This visual summarizes the key distinctions between acute and chronic leukemia types and outlines the general diagnostic process.
Acute vs. Chronic Leukemia
Acute Leukemias
- Onset: Sudden & Aggressive
- Progression: Rapid, requires immediate treatment
- Examples: ALL (children), AML (adults)
Chronic Leukemias
- Onset: Gradual & Less Aggressive
- Progression: Slower, may lack significant symptoms
- Examples: CLL (older adults), CML (Philadelphia chromosome)
Leukemia Diagnostic Process
- Blood Tests:Check for abnormal cell counts (e.g., Complete Blood Count - CBC).
- Bone Marrow Biopsy:Examine marrow directly for leukemia cells.
- Cytogenetic Tests:Identify genetic abnormalities specific to leukemia types.
Understanding Leukemia: An Overview of Types and Their Characteristics
Leukemia is a complex disease that affects the blood and bone marrow, leading to the production of abnormal blood cells. At What Is Leukemia, I aim to provide you with a clear understanding of this condition, helping to demystify its various forms and symptoms. Think of leukemia as a disruption in the harmonious orchestra of your blood—where some instruments play out of tune, leading to chaos in your body.
Understanding the fundamentals of leukemia is essential for anyone navigating this journey. By breaking down the different types, we empower patients, families, and caregivers with knowledge that can alleviate fear and promote informed decision-making.
Defining Leukemia: What You Need to Know
Leukemia can be primarily categorized into two types: acute and chronic. Each type varies in the speed of progression and the age group predominantly affected. Acute leukemias often require immediate treatment, while chronic leukemias may develop over a longer period, sometimes without significant symptoms. For a comprehensive look at leukemia types and their characteristics, you can refer to an overview of leukemia.
- Acute Leukemias: Sudden onset and aggressive progression.
- Chronic Leukemias: Gradual development and may be less aggressive.
- Lymphocytic vs. Myeloid: Refers to the type of white blood cells affected.
Recognizing these distinctions can be vital for early diagnosis and effective treatment. As someone deeply passionate about patient education, I believe that understanding these basics can help you feel more in control and prepared for discussions with your healthcare team.
Importance of Knowing Different Types of Leukemia
Each type of leukemia has unique characteristics, and knowing these can dramatically change the course of treatment and management. This knowledge helps in identifying symptoms and seeking timely medical attention. For instance, symptoms for one type might be entirely different from another, making awareness key in navigating your health journey.
- Informed Choices: Knowledge leads to better treatment decisions.
- Community Support: Understanding fosters a sense of community among patients.
- Empowerment: Knowledge replaces fear with confidence.
By understanding the various types of leukemia, you can better advocate for yourself or your loved ones. I encourage you to take this opportunity to become well-informed, as it can lead to a more proactive approach to managing your health.
Leukemia Diagnosis: How is It Performed?
Diagnosing leukemia typically involves a series of tests and procedures designed to evaluate your blood and bone marrow. The process can seem daunting, but knowing what to expect can ease some of the apprehension. These methods help healthcare professionals determine the specific type of leukemia and devise a tailored treatment plan. For detailed information on diagnostic practices, the National Center for Biotechnology Information (NCBI) provides extensive resources.
Commonly, a diagnosis may include:
- Blood tests to check for abnormal cell counts.
- Bone marrow biopsy to examine the bone marrow directly.
- Cytogenetic tests to identify genetic abnormalities.
Common Tests and Procedures in Diagnosing Leukemia
Understanding the tests involved in diagnosing leukemia can help you feel more prepared during consultations. Here are some of the most common diagnostic procedures:
- Complete Blood Count (CBC): Measures the levels of red and white blood cells, and platelets.
- Bone Marrow Aspirate and Biopsy: A sample of bone marrow is taken to look for leukemia cells.
- Imaging Studies: X-rays, CT scans, or MRIs may be performed to check for organ enlargement.
Being informed about these diagnostic methods is a significant step in your journey. It empowers you to ask informed questions and engage with your healthcare team actively. Remember, you are not alone in this process, and at What Is Leukemia, we are here to support you in your quest for understanding and hope.
Frequently Asked Questions About Leukemia
- Q: What are the main types of leukemia?
- A: Leukemia is primarily categorized into acute and chronic types. Acute leukemias are characterized by sudden onset and rapid progression, while chronic leukemias develop gradually and may be less aggressive. Both acute and chronic types are further classified as lymphocytic or myeloid, depending on the type of white blood cells affected.
- Q: What is the difference between acute and chronic leukemia?
- A: Acute leukemia progresses rapidly and requires immediate treatment, often affecting children (e.g., ALL) or adults (e.g., AML). Chronic leukemia progresses slowly, may have subtle symptoms, and is more common in older adults (e.g., CLL, CML).
- Q: How is leukemia diagnosed?
- A: Diagnosis typically involves a series of tests including Complete Blood Count (CBC) to check for abnormal cell counts, bone marrow aspirate and biopsy to examine the marrow directly for leukemia cells, and cytogenetic tests to identify specific genetic abnormalities.
- Q: Why is it important to know the specific type of leukemia?
- A: Knowing the specific type of leukemia is crucial because each type has unique characteristics, symptoms, and treatment pathways. This knowledge guides healthcare professionals in devising a tailored and effective treatment plan, and it empowers patients to make informed decisions and advocate for their care.
- Q: What role do clinical trials play in leukemia treatment?
- A: Clinical trials are essential for advancing leukemia treatment by providing access to cutting-edge therapies that may not yet be widely available. Participating in a clinical trial can offer innovative treatment options and contributes significantly to medical research and the broader fight against leukemia.
We Want to Hear From You!
What do you think about the importance of understanding different leukemia types? Share your thoughts below:
Summarizing the Types of Leukemia and Their Differences
As we've explored throughout this article, understanding the different types of leukemia is essential for patients and their families. Each type, from Acute Lymphocytic Leukemia (ALL) to Chronic Myeloid Leukemia (CML), has its unique characteristics, symptoms, and treatment pathways. This knowledge not only empowers patients but also paves the way for informed conversations with healthcare providers.
Here are some key takeaways to help summarize our discussion on leukemia types:
- ALL is primarily aggressive and often seen in children.
- AML usually affects adults and presents rapidly.
- CLL tends to progress slowly and is more common in older adults.
- CML is characterized by the Philadelphia chromosome and requires ongoing management.
Being aware of these distinctions can significantly impact treatment decisions and outcomes. As your advocate in this journey, I encourage you to reflect on how each type resonates with your situation or that of a loved one.
Encouraging Continued Education and Support for Patients
Knowledge is power, especially when navigating the complexities of leukemia. I believe that continued education is vital, not just for patients, but also for families and caregivers. Engaging with reliable resources like What Is Leukemia can provide ongoing support and updates about advancements in treatment options.

Remember, you are not alone. Here are a few ways to foster your education and support:
- Participate in local or online support groups.
- Attend educational webinars or workshops.
- Read up-to-date articles on leukemia and treatment.
- Connect with healthcare professionals for personalized guidance.
These steps not only enhance understanding but also create a supportive community where experiences and insights can be shared. Your journey with leukemia can be made less daunting through informed choices and connections.
Taking Action: Next Steps for Those Affected by Leukemia
Importance of Consulting Healthcare Professionals
One of the most crucial steps after a leukemia diagnosis is consulting with healthcare professionals. They can provide tailored advice and treatment plans that are specific to your leukemia type. It's important to choose a healthcare team that you feel comfortable with and who respects your preferences in treatment.
Don’t hesitate to ask questions or seek second opinions when necessary! Here are some key points to remember when engaging with your healthcare team:
- Be open about your concerns and symptoms.
- Inquire about the latest treatment options.
- Discuss potential clinical trials you might qualify for.
- Ask about support services available through the healthcare facility.
By being proactive in your healthcare, you can advocate for yourself and ensure that your voice is heard.
How to Seek Support and Resources for Leukemia
Seeking support is an important part of coping with a leukemia diagnosis. Various resources are available to help you, ranging from educational material to emotional support networks. Here’s how you can start:
- Reach out to leukemia support organizations such as the Leukemia & Lymphoma Society.
- Join community groups or forums focused on leukemia experiences.
- Utilize online platforms that offer resources and advice.
- Consider speaking with a counselor or therapist who specializes in chronic illness.
Connecting with others who understand your journey can provide immense comfort and guidance. It's vital to remember that sharing your feelings and experiences can lighten the emotional load.
Understanding Clinical Trials and Their Importance in Leukemia Treatment
Clinical trials play a significant role in advancing leukemia treatment. They allow patients access to cutting-edge therapies that may not yet be widely available. Participating in a clinical trial can be a way to contribute to medical research while potentially benefiting from innovative treatment options. For more information on leukemia research and clinical trials, the National Cancer Institute is an excellent resource.
Before considering a clinical trial, here are some steps to keep in mind:
- Consult with your healthcare team about available trials.
- Understand the eligibility criteria and what participation entails.
- Weigh the potential risks and benefits of joining a trial.
- Stay informed about the results and implications of ongoing research.
Being involved in clinical trials not only helps you but also contributes to the broader fight against leukemia.
Patient Advocacy and Resources: Support Organizations to Consider
Advocacy is a powerful tool in the fight against leukemia. Numerous organizations are dedicated to supporting patients through education, resources, and community engagement. Here are several organizations worth considering:
- The Leukemia & Lymphoma Society
- American Cancer Society
- Blood Cancer Network
- Leukemia Research Foundation
Engaging with these organizations can provide you with valuable resources for education, support, and advocacy. Remember, your voice matters in this journey. By connecting with others and seeking the necessary resources, you can navigate the complexities of leukemia with more confidence and support!
Recap of Key Points
Here is a quick recap of the important points discussed in the article:
- Types of Leukemia: Understand the differences between acute and chronic leukemia, as well as lymphocytic and myeloid classifications.
- Diagnosis Methods: Familiarize yourself with common diagnostic tests such as blood tests, bone marrow biopsies, and cytogenetic tests.
- Informed Choices: Knowledge about leukemia types enables better decision-making regarding treatment options.
- Community Support: Engaging with support groups and reliable resources fosters a sense of community among patients.
- Advocacy: Be proactive in consultations with healthcare professionals to ensure personalized care and treatment plans.
Popular Posts
A staggering 70% of cancer patients report experiencing debilitating fatigue, but what does that rea
Consider this: the journey through leukemia recovery can be daunting, but understanding stem cell tr
Did you know that approximately 21,000 new cases of Chronic Lymphocytic Leukemia (CLL) are diagnosed
Are you aware that understanding your treatment options can significantly reduce anxiety during a le